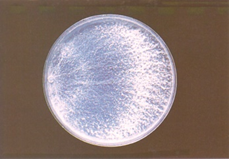
image.png

桦褐孔菌宏观描述:1 周生长:菌落半径 35-40 毫米。垫白色。推进区相当均匀。气生菌丝体表膜。2 周生长:盖板。垫白色。气生菌丝体表皮至绒毛。6 周生长:垫白色。气生菌丝体表皮,稍带状。气味发霉。琼脂棕色。不结果。
桦褐孔菌微观描述:菌丝系统二聚体。前生菌丝无色,直径2.5-5.5 μm,壁稍厚,具节状分隔。气生菌丝骨架菌丝无色,直径1.5-4.5克,壁稍厚,疏分枝;气生菌丝无色,直径2.5-4微米,壁薄至稍厚,具节状有隔,中度分枝。沉水菌丝无色,直径1.5-5微米,壁薄至略厚,具节状分隔,中度分枝。存在晶体。

桦褐孔菌子实体
桦褐孔菌在 25 °C 下在 1.5% MEA 上生长 6 周后的培养

桦褐孔菌在 25 °C 下在 1.5% MEA 上生长 2 周后培养

桦褐孔菌在不同温度下的生长速度。

发表评论